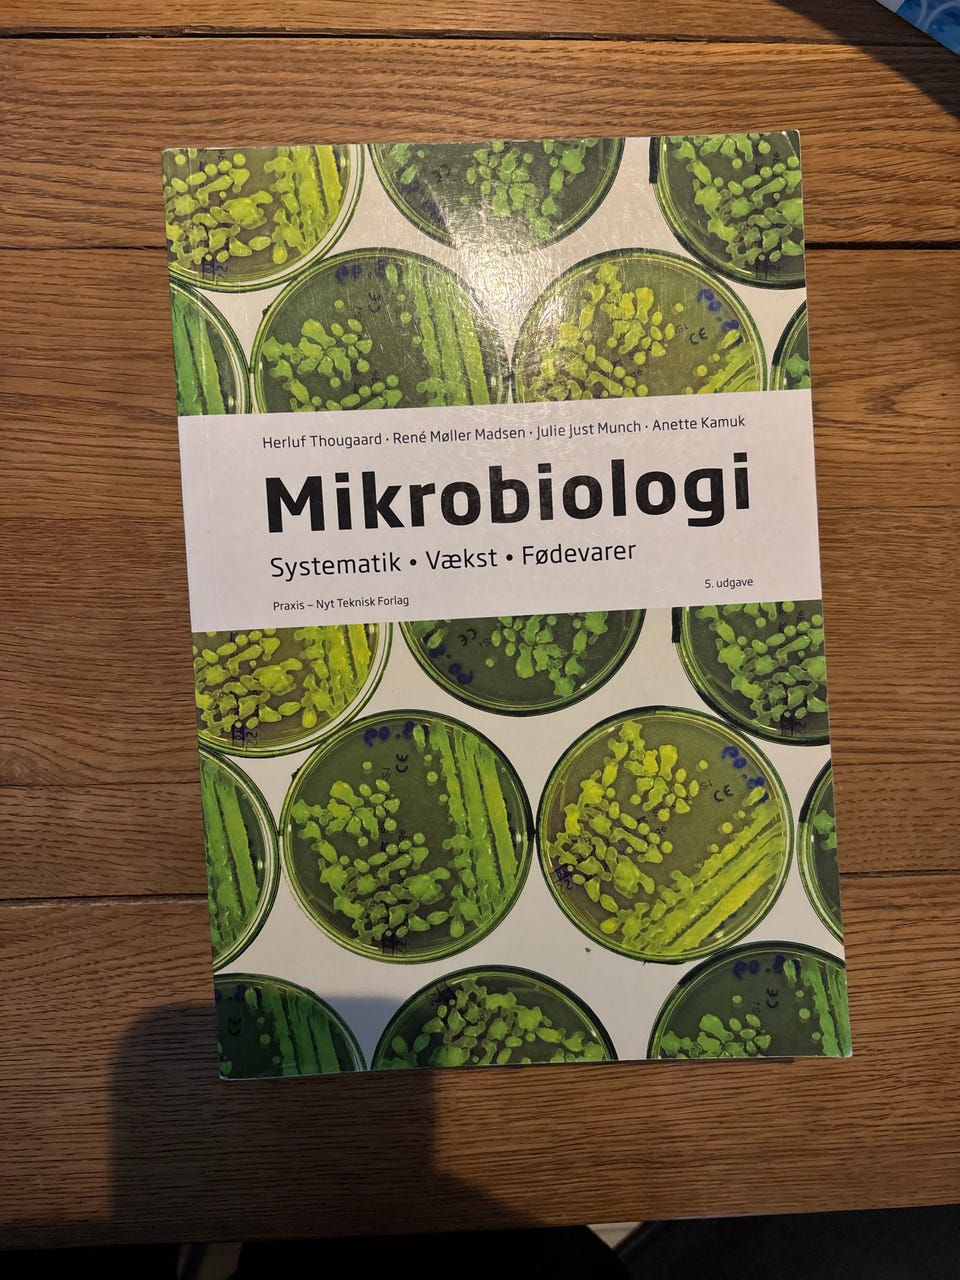
Galleribillede

Billedgalleri
(1/1)
Mikrobiologi Systematik Vækst Fødevarer Andre studiebøger
Til salg
200 kr.
Bed sælgeren om at sende med Fiks færdig! Det er trygt, hurtigt, og varen vil blive sendt til dig. Læs mere
Varebeskrivelse
Stand: Brugt - men i god stand
Emne: Andre studiebøger
Mikrobiologi Systematik Vækst Fødevarer er en studiebog inden for mikrobiologi, der omhandler systematik, vækst og fødevarer. Bogen er relevant for studerende og fagfolk, der ønsker viden om mikroorganismer og deres anvendelse i fødevareindustrien.
Laborantudannelsen
Se mine andre annoncer med studiebøger
Bemærk: Knappen til at vise den fulde beskrivelse har kun en visuel effekt.
Brugerprofil

Du skal være logget ind for at se brugerprofiler og sende beskeder.
Log indAnnoncens metadata
Sidst redigeret: 14.3.2026 kl. 08:04 ・ Annonce-ID: 18236313